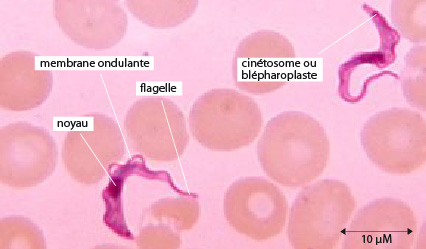

Nous vivons parmi la multitude insoupçonnée de ces organismes unicellulaires. Les uns nous sont indifférents, d'autres utiles, certains nuisibles. Parmi ces derniers, Plasmodium falciparum est l'agent causal de la malaria (ou paludisme), la maladie parasitaire la plus dommageable à l’homme.
Comment des êtres unicellulaires parviennent-ils à réaliser les grandes fonctions vitales ? Nous étudierons la grande diversité des structures qui leur permet de se mouvoir, de se protéger, de se nourrir, d'équilibrer leur osmolarité et de se reproduire.
Ensuite la diversification des Protistes en différents Règnes, leur parenté avec les autres grands groupes d'êtres vivants, et l’origine de la vie animale pluricellulaire (les Métazoaires) seront esquissées.
- Eucaryotes, pour la plupart unicellulaires
- Taille variable, de 1µm à plusieurs mm
- Groupe d’eucaryotes paraphylétique: certains sont plus étroitement apparentés aux Végétaux, certains aux Champignons et d’autres aux Animaux
- Formes libres et parasites
- Les formes libres vivent dans tout type d’environnement : mer, eau douce, sol, etc.
- Mode de nutrition diversifié : photo-autotrophes, hétérotrophes, mixotrophes
- Mode de reproduction diversifié : asexué, sexué, asexué et sexué.

Les Protistes, comme cette Paramécie, sont des eucaryotes essentiellement unicellulaires ; ils possèdent donc, entre autres caractéristiques, un noyau isolé dans un système de membranes.
On connaît 215,000 espèces de Protistes qui assurent près de 40% de la productivité mondiale primaire. Ils sont donc omniprésents dans notre environnement. On retrouve d’ailleurs des protistes photosynthétiques (comme les plantes) souvent nommés protophytes, ces organismes sont autotrophes. Les protozoaires sont les protistes hétérotrophes qui ingèrent leur nourriture par phagocytose. On en discutera plus à la fin de ce chapitre dans la partie diversité.

Ils sont présents dans la plupart des milieux humides. Les Protistes marins forment une bonne partie du plancton qui alimente un grand nombre d'animaux, notamment les baleines.
Le plancton est cet ensemble d'organismes de très petite taille, des unicellulaires ou des pluricellulaires, adultes ou larvaires qui flottent ou nagent faiblement à la surface des eaux. Les flèches blanches indiquent les unicellulaires. Les autres animaux planctoniques de cette image sont des pluricellulaires.

Parmi ces Protistes planctoniques, certains possèdent un squelette. Ils ont joué un rôle majeur dans l'histoire géologique du globe terrestre. A leur mort, le squelette tombe sur le fond des océans.

Ainsi, ils ont contribué peu à peu à la formation de couches sédimentaires, dont les falaises d'Etretat en France sont un exemple.

On trouve aussi des Protistes dans les eaux douces et dans le sol. Ils y décomposent les déchets organiques et ré-enrichissent ainsi leur milieu en éléments minéraux. Ils se multiplient très rapidement dans les biotopes pollués et certains d'entre eux sont d'ailleurs utilisés comme indicateurs de pollution.

Ce ne sont pas les seuls milieux humides colonisés par les Protistes. Le tube digestif des animaux est aussi un milieu propice à leur multiplication. Des centaines d'espèces, comme celle représentée sur cette image, vivent en symbiose dans le système digestif de certains insectes, les termites par exemple, et des mammifères herbivores. Dans cette association, les deux partenaires trouvent leur bénéfice, il s'agit alors d'un cas de mutualisme. Nous en reparlerons plus tard.
Un autre cas de symbiose est le parasitisme. Ici, un seul des deux partenaires, le parasite trouve son compte dans l'association. Au total, il y a probablement 5000 espèces de Protistes parasites. Quelques plantes, mais surtout les animaux pluricellulaires leur fournissent des habitats favorables.

(a) Tetrahymena thermophila
(b) Paramecium sp. et Didinium sp.
(c) Oxyrrhis sp.
(d) Trypanosoma sp.
(e) Dictyostelium sp.
(f) le Choanoflagellé Monosiga brevicollis.
(Photos reprises de Montagnes et al (2012) dans le journal Trends in Microbiology).

Il existe plusieurs types de pollution des eaux de rivière.
En ce qui concerne la pollution organique (eaux d'égout, rejets d'usines alimentaires telles que laiteries, abattoirs, etc.), voici la succession des événements qui se produisent: sur le site de pollution, on constate une activité bactérienne intense, avec une forte consommation d'oxygène. La plupart des organismes eucaryotes ne survivent pas; ils disparaissent donc de la faune habituelle de la rivière. Parmi les Protistes, les Flagellés Bodo et Oikomona, consommateurs de bactéries, survivent généralement bien.
A quelques distances de là, l'activité bactérienne a enrichi l'eau en sels minéraux, ce qui est favorable au développement des algues photosynthétiques; celles-ci prolifèrent et contribuent à réoxygéner le milieu. Les Ciliés herbivores et les Amibes réapparaissent. Petit-à-petit, toute la chaîne alimentaire se reconstitue.
Les stations d'épuration reproduisent ces procédés naturels, mais le processus est accéléré et isolé du courant.

Vous voyez ici Plasmodium sp. en microscopie électronique. Il est l'agent de la malaria chez l'homme.
Dans notre arbre de la vie il fait partie du clade des chromoalvéolés. Au sein des chromoalvéolés on les retrouve chez les Apicomplexés ou sporozoaires qui sont des eucaryotes unicellulaires, tous parasites extracellulaires ou intracellulaires d’animaux, qui forment au cours de leur cycle vital des spores (ou zoïtes). Ces spores servent à la dissémination et à la transmission de l’espèce d’un hôte à l’autre. Nous le verrons lors du cycle de vie du Plasmodium sp.

La malaria ou paludisme est surtout caractérisée par une fièvre périodique. La victime est terrassée par une crise de fièvre au milieu du premier jour de la maladie. Cette fièvre tombe vers minuit et le malade semble guérir. Hélas, au milieu du 3ème jour, une nouvelle poussée de fièvre survient, elle aussi suivie d'un répit de 48 heures et ainsi de suite. C'est la fièvre tierce. Pour une autre forme de malaria, la fièvre quarte, la seconde poussée de fièvre se produit le 4ème jour de la maladie.
Cette fièvre s'accompagne d'un gonflement du foie et de la rate et d'une anémie sévère. Cette maladie ne tue pas tout de suite la personne atteinte, mais l'affaiblit considérablement et la rend vulnérable. De plus, dans certaines malarias, des capillaires sont obstrués et les organes qu'ils irriguent subissent des troubles graves de fonctionnement. Le site de l'organisation mondiale de la santé vous fournit d'autres informations sur cette maladie.

Actuellement, l'extension géographique de la malaria peut être représentée comme sur cette carte. Chaque année, 300 millions d'individus nouveaux sont atteints, et l'on peut dire que 2 milliards d'êtres humains sont concernés par le paludisme. En 2010, le paludisme a été à l’origine de 660 000 décès (avec une marge d’incertitude comprise entre 490 000 et 836 000), pour la plupart parmi les enfants africains (Source OMS). Ces terribles chiffres suffisent à montrer l'importance du problème. Mais autrefois, le paludisme n'était pas la maladie strictement tropicale qu'il est devenu. Il sévissait dans le bassin méditerranéen. Des formes bénignes existaient aussi plus au nord. En Belgique et en Hollande, on l'appelait fièvre des Polders, car elle ne se rencontrait qu'en bordure de la côte.
Chose curieuse, le remède a été connu bien avant la cause. L'écorce d'un arbre, le quinquina a été utilisée avec succès dès le 17ème siècle et son extrait, la quinine, plus tard. Mais la découverte de l'agent responsable de la malaria, et de son mode de transmission, s'est fait longtemps attendre. Les médecins se sont aperçus il y a seulement un peu plus de 100 ans que les moustiques jouaient un rôle essentiel dans le cycle de vie de la malaria. Actuellement, un phénomène de résistance aux traitements existants apparait dans certaines zones touchées par le parasite.

Un Français, Lavéran, découvrit en examinant soigneusement et longuement une goutte de sang d'un malade sous le microscope, des êtres vivants entre les globules rouges.
Par la suite, on découvrit qu'il existait quatre espèces différentes de Plasmodium, chacune responsable d'une forme de paludisme humain, Plasmodium malariae, Plasmodium vivax, Plasmodium ovale et Plasmodium falciparum. Ce dernier est le seul mortel mais le plus répandu. Leur transmission n'est possible que par certaines espèces de moustiques femelles du genre Anophèle.
Le cycle vital du Plasmodium falciparum est complexe. Il permet de comprendre premièrement le grand problème biologique qu'est la relation entre l'hôte et son parasite, et deuxièmement de concevoir des moyens de lutte adéquats.

Ce schéma résume le cycle de vie de Plasmodium sp, qui se déroule en partie dans le premier hôte (les moustiques femelles du genre Anopheles sp; partie supérieure du schéma) et en partie dans le second hôte, l’homme (partie inférieure du schéma).
En 1, on découvre l’agent pathogène de Plasmosdium, c-à-d le stade infectieux haploïde du cycle de vie qui est capable d’infecter l’humain. On l’appelle le « sporozoïte » et il fait 1 µm de long. Les sporozoïtes passent dans l’homme via la piqure du moustique infecté et migrent vers le foie où ils pénètrent dans les hépatocytes (ou cellules hépatiques du foie).
En 2, dans les hépatocytes, les sporozoïtes se divisent plusieurs fois par fission ou multiplication asexuée (la schizogonie) aboutissant en un schizonte mur. Ce schizonte primaire éclate afin d’émettre des mérozoïtes qui rejoignent le sang.
En 3, chaque mérozoïte pénètre dans un globule rouge où il se nourrit du cytoplasme riche en hémoglobine, par endocytose. Il se multiplie par reproduction asexuée à l’intérieur du globule rouge pour ainsi former un schizonte (secondaire). Le schizonte éclate et relâche dans le sang des mérozoïtes qui peuvent envahir de nouveaux globules rouges. Les globules rouges parasités éclatent en même temps et provoque les accès de fièvre.
En 4, ces mérozoïtes peuvent entamer une phase de reproduction sexuée et devenir des gamétocytes mâles et femelles haploïdes qui vont demeurer dans le sang.
En 5, les gamétocytes absorbés par un moustique femelle Anophèle se développent, ceux qui restent dans le sang de l’homme se dégénèrent. Dans le tube digestif du moustique les gamétocytes vont fusionner et former un zygote diploïde.
En 6, le zygote perfore l'épithélium intestinal du moustique et s’y enkyste formant un oocyste. A l’intérieur de l’oocyste le zygote subit une caryocinèse sans cytocinèse. Les noyaux issus sont haploïdes: il s'agit donc d'une méiose. Ces noyaux haploïdes se divisent encore par mitoses pour former finalement quelques milliers de cellules allongées: les sporozoïtes. L’oocyste éclate et libère les sporozoïtes qui sont drainés par la circulation de l'insecte vers les glandes salivaires du moustique.
Lorsque ce moustique pique un homme, il lui injecte un petit lot de sporozoïtes... et le cycle de vie est bouclé !
La phase de reproduction sexuée est souvent nommé gamétogonie chez les protozoaires, la phase de reproduction asexuée est la schizogonie.

Les larves de moustique sont peut-être accessibles pour lutter contre cette maladie. Elles vivent à la surface de l'eau, dans les marais, les étangs et mêmes les petites flaques. Pendant de nombreuses années, on a essayé d'éliminer ces gîtes en drainant les marais, en asséchant les petites pièces d'eau ou en étalant une couche de pétrole sur l'eau pour asphyxier les larves. Ces moyens, aussi efficaces qu'ils soient contre les moustiques, ont des gros inconvénients. L'épandage de pétrole a fait un tort immense à la faune et à la flore. De nombreux pays en voie de développement tentent une révolution verte pour surmonter leur handicap économique et irriguent pour ce faire de nouvelles zones qui deviennent favorables à la prolifération de moustiques ; un exemple parmi d’autres de cultures et élevages provoquant le retour de la malaria en Asie du Sud Est : les scampis de type « Tiger » en vente à des prix imbattables dans tous nos supermarchés... à quel prix pour les populations locales ?
Lorsque le DDT, insecticide chimique, produit par la firme Monsanto, est arrivé sur le marché peu après la seconde guerre mondiale, des résultats spectaculaires ont été obtenus grâce à sa pulvérisation massive. Le paludisme a régressé, il a été éliminé de nombreuses régions et éradiqué des zones tempérées. Chercheurs et experts croyaient la bataille presque gagnée, ce qui ne favorisa pas la recherche dans d'autres directions. Mais vingt ans après l'offensive, tout le terrain gagné était à peu près perdu. En effet, un phénomène de résistance des moustiques au DDT est apparu. L'utilisation excessive de DDT a sélectionné les moustiques résistants. Par ailleurs, le DDT s’est avéré extrêmement nocif pour tous les organismes vivants. Il a donc été interdit en 1972. De nouveaux insecticides ont bien été fabriqués, mais outre leur coût beaucoup plus élevé, ils ont, eux aussi, provoqué des résistances.
D'autres tentatives de lutte contre le moustique ont été imaginées et testées en laboratoire. Favoriser la multiplication des prédateurs de larves de moustiques, tels certains poissons; il faudra ici faire attention de ne pas bouleverser l'équilibre écologique. Infester les larves par une bactérie parasite, inoffensive pour les autres animaux. Le coût de l'opération est très élevé puisqu'elle doit être répétée très souvent pour un bon résultat. Stériliser un nombre suffisant de moustiques mâles, par irradiation ou chimiquement, puis les relâcher dans la nature afin qu'un bon nombre d'accouplements ne donnent pas de rejetons. Hélas les mâles stériles ne sont pas attractifs pour les moustiques femelles.
Si le parasite ne peut être combattu au travers du moustique, c'est chez l'homme qu'il faut le traquer. Différents médicaments sont apparus sur le marché, le plus utilisé restant la quinine, qui empêche le « sporozoïte » de se nourrir en bloquant le fonctionnement de ses lysosomes. Mais là aussi, une résistance au médicament est apparue. D'autres anti-malariques, de synthèse cette fois, sont sur le marché telle que la Malarone® développée et mise sur le marché par la compagnie wallonne GSK en 2000. Le risque d’apparition de résistances à ces nouveaux médicaments n'est toutefois pas écarté.
Le besoin d'un vaccin antipaludéen n'a donc jamais été ressenti aussi fortement qu'aujourd'hui. Aussi plusieurs équipes de chercheurs de par le monde travaillent dans ce but. Une des premières étapes indispensables pour mener à bien ce projet a été de cultiver le parasite in vitro pour posséder le matériel de base des expériences. La mise au point d’un vaccin anti-malarique est un but qu’on peut espérer atteindre dans les années à venir.

Voici un dessin du trypanosome Trypanosoma brucei, causant la maladie du sommeil. Les trypanosomes sont des protistes parasites flagellés dans les voies digestives des invertébrés et le sang des vertébrés. Les espèces les plus connues étant pathogènes chez l’humain sont Trypanosoma brucei et Trypanosoma cruzi. On les retrouve au sein du clade des Excavobiontes (partie diversité à la fin du chapitre).
Le parasite de la maladie du sommeil est le protozoaire Trypanosoma brucei qui est transmis à l’homme par la piqûre d’une mouche tsé-tsé (du genre Glossina) qui s’est elle-même infectée chez l’homme ou chez un animal porteur du parasite pathogène pour l’homme.
On trouve uniquement les mouches tsé-tsé en Afrique subsaharienne et seules certaines espèces transmettent la maladie. Les populations humaines les plus exposées à la mouche tsé-tsé, et par conséquent à la maladie, sont les populations rurales qui dépendent de l’agriculture, de la pêche, de l’élevage ou de la chasse. Les animaux sauvages et domestiques, et en particulier le bétail, peuvent abriter ces parasites et font dès lors office de réservoir. Toutefois, le rôle épidémiologique exact de ce réservoir demeure assez mal connu.

En 1, une mouche tsé-tsé infectée (genre Glossina) transmettra, pendant un repas de sang sur le mammifère hôte, les formes trypomastigotes métacycliques du parasite. La piqûre est ressentie comme une aiguille chaude enfoncée dans la chair.
En 2, à l'intérieur de l’hôte, les trypomastigotes de T. brucei sont transportés vers les différents fluides biologiques : sang, lymphe et par la suite (en absence de traitement) vers le liquide céphalo-rachidien.
En 3, les trypomastigotes se multiplient par scissiparité (reproduction asexuée) dans les différents fluides biologiques. Le parasite reste extra-cellulaire, contrairement au plasmodium qui pénètre dans les globules rouges ou le Trypanosoma cruzi qui envahit les cellules de différents tissus pour se reproduire.
En 4, les trypomastigotes sont présents dans le sang de l’homme.
En 5, une mouche tsé-tsé s’infecte par des trypomastigotes en prenant un repas de sang sur un mammifère infecté.
En 6, dans l’intestin de la mouche, les parasites se transforment en trypomastigotes procycliques qui s’y multiplient par scissiparité.
En 7, les trypomastigotes quittent l’intestin et se transforment en épimastigotes. La forme épimastigote est une autre forme cellulaire du parasite.
En 8, les épimastigotes atteignent les glandes salivaires de la mouche, s’y multiplient par scissiparité et se transforment en trypomastigotes métacycliques. Le cycle dans la mouche dure approximativement 3 semaines.

Chez Trypanosoma brucei on ne retrouve que les formes cellulaires qui ont un long flagelle, nommées trypomastigotes et épimastigotes. Il existe chez les trypanosomes également la forme cellulaire amastigote ou promastigote mais pas chez Trypanosoma brucei. Ces formes cellulaires sont importantes dans le diagnose de la maladie par les médecins.
Trypanosoma brucei cause la maladie du sommeil chez l’humain. Au cours du premier stade de la maladie, les trypanosomes se multiplient dans le système sanguin et lymphatique. Les premiers symptômes se caractérisent par des poussées de fièvre, des maux de tête, et des douleurs articulaires. Comme les parasites pénètrent également dans le système lymphatique, les ganglions lymphatiques gonflent souvent et atteignent des tailles énormes. En l’absence de traitement, on passe dans la seconde phase de la maladie au cours duquel le parasite a franchi la barrière hémato-encéphalique et a envahi le système nerveux central. On entre alors dans la phase des troubles neurologiques qui correspond à l’apparition des symptômes manifestes de la maladie : confusion mentale, mauvaise coordination, troubles sensoriels et cycle du sommeil perturbé. En l’absence de traitement, la maladie du sommeil est mortelle.
Si on détecte rapidement la maladie, on peut facilement la traiter. La plus grande partie des personnes touchées vivent dans des régions reculées et n’ont qu’un accès limité aux services de santé appropriés, ce qui fait obstacle à la surveillance et par conséquent au diagnostic et au traitement. Néanmoins ces dernières décennies plusieurs organismes et partenariats public-privé ont apporté un soutien aux pays touchés en aidant dans les actions de dépistage, pour rechercher l’infection potentielle dans un stade précoce, et en fournissant gratuitement des médicaments. Le succès rencontré a fait diminué le nombre de cas de maladie du sommeil et a encouragé d’autres partenaires du secteur privé à soutenir l’effort visant à éliminer la maladie en tant que problème de santé publique. Après des efforts de lutte incessants, le nombre des cas notifiés en 2009 est passé en dessous de 10 000 pour la première fois en 50 ans. Cette tendance s’est poursuivie en 2010 avec apparemment 7139 nouveaux cas notifiés. On estime actuellement le nombre de cas effectifs à environ 30 000 personnes (chiffre de Octobre 2012 - OMS).
Néanmoins on observe également chez le trypanosome des apparitions de résistance accrue aux médicaments donnés. Par ailleurs, les trypanosomes peuvent échapper a la détection immunologique grâce a un mécanisme efficace: les protéines membranaires (des glycoprotéines) sont souvent changées afin d’échapper au système immunitaire de son hôte.

Cette image montre un ensemble de squelettes de Foraminifères. La flèche indique le squelette d'une globigérine.
Ce groupe des Foraminifères est très important, il représente la moitié du nombre d'espèces décrites chez les Protistes. Ces coquilles de carbonate de calcium sont généralement bien fossilisables. La diversité de leurs formes fait des Foraminifères un outil essentiel pour le repérage et la datation des couches géologiques.
Très souvent, leur squelette est composé d'une succession de logettes de taille croissante. La globigérine commence son cycle vital dans une coquille à une seule chambre, mais, lorsque la taille de l'animal croît, le cytoplasme déborde par l'ouverture de la première chambre et sécrète un autre compartiment plus large. Ce processus se poursuit tout au long de la vie du Protiste. L'addition de nouvelles chambres, peut se réaliser selon une disposition symétrique, en spirale par exemple pour arriver à une forme semblable à celle d'une coquille d'escargot. D'autres dispositions sont possibles aussi, comme cet arrangement selon deux axes ou en ligne droite, ou encore en pelure d'oignon.
Ceci est un exemple de tégument d'un groupe de protistes, nous n'allons pas élaborer cette partie.

Les protistes ont différents moyens de locomotion : les flagelles (ex. le trypanosme ou volvox), les cils (ex. la paramécie), la formation de spores par les protistes parasites (tel que le plasmodium) et les pseudopodes (ex. l’amibe).
Commencons par le flagelle. Sa structure vous est déjà familière puisque vous l'avez déjà étudiée. Aussi nous nous contenterons de la revoir rapidement. Le flagelle, tout comme le cil, sont composés d'une armature de microtubules du type 9+2; 9 doublets de microtubules en cercle et 2 microtubules centraux. Cette armature est engendrée par un kinétosome (voir Fig. Pr. 2.10). Elle porte et meut par battement une évagination de membrane plasmique en doigt de gant: la hampe.
Un autre moyen de locomotion chez les Protistes sont les cils. Les cils ont la même structure que les flagelles. C'est l'occasion de souligner que la possession de flagelles ou de cils n'est pas l'apanage des Protistes puisque la plupart des eucaryotes possèdent des gamètes flagellés ou des cellules ciliées.

Les forces latérales (lignes bleues) s’annulent tandis que les forces longitudinales (flèches noires) se combinent pour produire le déplacement.
La disposition et le fonctionnement du flagelle sont divers. Le flagelle peut être direct, dans le prolongement du corps et de son point d'insertion. Ce flagelle peut se mouvoir dans un seul plan. Des ondulations se déplaçant de sa base vers le sommet propulsant l'animal à la manière d'une godille de bateau (comme sur la figure ci-contre). Des ondulations se déplaçant du sommet du flagelle vers sa base attirent le Protiste en sens inverse à la manière d'une hélice d'avion. Le déplacement du flagelle peut aussi se produire dans les trois plans de l'espace, et le Protiste avance en spirale par exemple.
Chez le trypanosome, le flagelle prend son origine au niveau du kinétosome situé à l’arrière du noyau. Le kinétosome est associé au kinétoplaste, partie de la mitochondrie qui fournit l’énergie nécéssaire au mouvement du flagelle. Le flagelle rejoint l’extrémité antérieure du protiste en passant sous la membrane plasmique qui devient la membrane ondulante sous les mouvements du flagelle. Le flagelle tire le trypanosome, il est dit tractelle.
En récoltant une eau de mare, on peut prélever notamment des Volvox. Ces Protistes flagellés vivent en colonie et forment une sphère, au sein de laquelle on voit d’autres sphères. Cet ensemble tourne sur lui-même et se laisse flotter. La coloration verte indique qu’il s’agit de Protistes pourvus de chloroplastes (des protophytes) et donc capables de photosynthèse. Chaque individu de la colonie est muni de deux flagelles. La coordination des flagelles rend possible le mouvement global de la colonie.

Le battement du cil est plus simple que celui du flagelle, il s'effectue toujours selon le schéma qui est présenté ici. La locomotion se produit par des vagues de battement qui courent à la surface des zones ciliées. Celles-ci sont composées de milliers de cils implantés en plusieurs rangées. Chez certaines espèces évoluées, l'efficacité de quelques zones ciliées est augmentée par l'association de cils voisins, au niveau des hampes et des kinétosomes. Ces complexes ciliaires ont la forme de pinceaux ou de rideaux.

Les Protistes Ciliés, comme la Paramécie, se déplacent grâce à l’action coordonnée de milliers de cils. Le cil se meut avec un battement puissant qui refoule l’eau vers l’arrière et un battement léger de retour. La coordination de ces mouvements dessine des ondes de battement à la surface du cilié. Vous voyez ici la trajectoire de nage d’une Paramécie à l’aide de cils.
Chez le protiste parasite tel que le plasmodium, la transmission d’un hôte vers l’autre se fait via la formation de « spores » ou sporozoîtes. Ce n’est pas une locomotion à proprement dit mais le stade infectieux produit par le parasite pour être transmis entre hôtes.

Les Sarcodines (amibes) sont des Protistes souples et déformables qui se déplacent en se déformant et en rampant. Elles émettent une languette appelée pseudopode . Ensuite, le reste du corps se contracte, se rétrécit, le cytoplasme est chassé dans le pseudopode qui s'élargit et s'allonge. Résultat: l'organisme occupe l'emplacement du pseudopode initial. Les pseudopodes sont temporaires, c'est-à-dire qu'ils sont susceptibles d'apparaître en un point quelconque de la surface de l'organisme et disparaître ensuite.
L’amibe a besoin d’être sur un support solide pour pouvoir avancer. Elle « rampe » sur son substrat. L’amibe n’est pas capable de se déplacer de façon coordonnée en étant libre dans l’eau. La vitesse de déplacement d’une amibe est de +/- 20mm/heure.

Cette image représente une globigérine vivante. Son squelette est criblé de minuscules trous qui livrent passage à des pseudopodes longs et grêles. Le squelette paraît donc circonscrit par un réseau de pseudopodes.

Chez les protistes on retrouve des modes de nutrition diversifiés: photo-autotrophes ou hétérotrophes.
Avant d'aborder la diversité des structures qui ont trait à la fonction de nutrition, voulez-vous établir une fois encore une comparaison entre les modes de nutrition autotrophe et hétérotrophe.
Il est clair que les organismes autotrophes et hétérotrophes diffèrent fortement entre eux, premièrement dans la nature des éléments nutritifs dont ils ont besoin, et deuxièmement dans la manière dont ils se les procurent.
Certaines espèces de Protistes possèdent des chloroplastes. L'énergie solaire y est transformée par la chlorophylle et est employée à l'élaboration de molécules organiques complexes à partir de matériaux inorganiques simples. Les espèces qui contiennent des chloroplastes sont donc autotrophes photosynthétiques. Chez les Protistes, c’est le cas de Volvox, ce protiste colonial flagellés visible dans les gouttes d’eau et qui est représenté ici sur l’image. C’est aussi le cas des Euglènes.

Les hétérotrophes, par contre, doivent localiser puis capturer leur proie puisqu’ils ne peuvent produire leur propre matière organique qu’à partir de la matière organique de leurs proies. L’hétérotrophie nécessite une plus grande activité pour se procurer les éléments nutritifs que l’autotrophie.
Les Protistes, bien qu'unicellulaires pour la plupart, ont cependant développé plusieurs méthodes très élaborées pour capturer leurs aliments. Les Amibes n'ont aucune structure digestive permanente. La particule phagocytée par l’amibe est entourée par les pseudopodes de la cellule, formant une nouvelle vacuole intracellulaire, la vacuole alimentaire ou phagosome . Ces phagosomes sont transitoires et disparaissent dès que la digestion est terminée. D'un point de vue fonctionnel, les phagosomes sont cependant analogues au système digestif d'animaux pluricellulaires complexes puisque la digestion est compartimentée dans une partie de l’organisme qui produit spécifiquement les enzymes de digestion. La nourriture est digérée à l'intérieur de la cellule, on parle de digestion intracellulaire.
L’amibe engloutit sa proie en l’enfermant dans ses pseudopodes, elle peut ainsi capturer des proies volumineuses, comme une Paramécie. Au début, la Paramécie se débat dans le phagosome, puis les lysosomes déversent leurs enzymes et la digestion commence. La vacuole alimentaire ou phagosome laisse diffuser les produits de digestion (acides aminés, sucres simples,...) à travers sa membrane, vers le cytoplasme.

Contrairement aux Amibes, la Paramécie possède une seule zone de phagocytose : le cytostome (invagination de la membrane plasmique formant une « cavité buccale » primitive pour un organisme unicellulaire). Cette portion de la membrane plasmique est généralement logée au fond d'une dépression, la cavité buccale ou péristome. La zone ciliée qui recouvre la cavité buccale (la ciliature orale) et ses environs immédiats sert surtout à amener la nourriture au cytostome. Les autres zones ciliées, qui couvrent tout ou partie du corps (la ciliature somatique), servent à mouvoir l'organisme. La digestion se fait selon une trajectoire précise et les résidus sont rejetés via un pore anal, lui aussi de position fixe. La Paramécie se nourrit principalement de bactéries par phagocytose.
Les organismes de petite taille tels que les Protistes n’ont pas besoin de structures spécialisées pour la respiration ou la circulation. La diffusion simple entre le milieu extérieur et le cytoplasme suffisent étant donné le grand rapport surface/volume pour les organismes de cette taille.
Les organismes de petite taille tels que les Protistes n’ont pas besoin de structures spécialisées pour la respiration ou la circulation. La diffusion simple entre le milieu extérieur et le cytoplasme suffisent étant donné le grand rapport surface/volume pour les organismes de cette taille.

Il n'y a aucune structure excrétrice chez de nombreux animaux unicellulaires. Les déchets azotés sont simplement excrétés au travers de la membrane plasmique dans l'eau environnante. Certains Protistes ont cependant un organite excréteur spécial, la vacuole pulsatile. C'est la tache circulaire nette, que l'on voit chez cette Amibe.
Chaque vacuole passe par un cycle régulier de remplissage et de vidange. Dans un premier stade, la vacuole se remplit de liquide et devient de plus en plus grosse, dans un second stade, elle se contracte et éjecte son contenu dans le milieu extérieur. Même si l'on sait maintenant que les vacuoles pulsatiles excrètent quelques déchets, il apparaît clairement que leur fonction première est l'élimination de l'excès d'eau.
Comme on peut le prédire si cette hypothèse est vraie, elles devraient être plus communes chez les formes d'eau douce qui se retrouve dans un environnement hypotonique que chez les formes marines. C'est bien ce que l'on peut constater. La fréquence de leur contraction devrait aussi être plus lente lorsque la concentration osmotique du milieu environnant s'accroît. De nouveau, c'est bien ce qui se produit.
Si la fonction principale des vacuoles pulsatiles est l'expulsion d'eau hors de la cellule, alors le fluide dans les vacuoles doit avoir une concentration osmotique plus faible que dans le cytoplasme. Cela a pu être confirmé par la prise d'échantillons dans la vacuole à l'aide de micropipettes.

Mais comment la vacuole peut-elle retenir l'eau alors que selon les règles de l'osmose, l'eau devrait en sortir ? Puisque l'eau elle-même ne peut être transférée par transport actif, il doit y avoir une autre explication.
La paramécie contient deux vacuoles pulsatiles. Une particularité de cette dernière est que ces deux vacuoles se remplissent ou se vide de façon alternée. La figure illustre bien que lorsqu’une vacuole est remplie, l’autre est vidé et vice versa.
Il n’y a pas de système nerveux chez les organismes unicellulaires tels que les Protistes.

Reproduction asexuée
La dernière fonction vitale que nous allons aborder n'est pas la moindre. C'est la fonction de reproduction. Il n’y a pas de « système » reproducteur à proprement parler chez les Protistes. Les Protistes se multiplient par reproduction asexuée ou sexuée. Dans le premier cas, il n’y a pas de remaniement du matériel génétique grâce à la méiose, mais bien dans le second.
Commençons par la reproduction asexuée, que pratique tout Protiste. La division d’une cellule mère en deux cellules filles peut intervenir directement par fission (chez l’Euglène). Si l’une des cellules filles est beaucoup plus petite que l’autre, on parle de bourgeonnement.
Un cas particulier de reproduction asexuée (ou clonale) concerne la phase de multiplication cellulaire dans le cycle de vie de Plasmodium, produisant de nombreux sporozoïtes issus de la division par caryocinèse, sans cytocinèse, du zygote (cf. phase 6 du cycle de vie). On parle dans ce cas de division multiple ou schizogonie. Chez le plasmodium on retrouve néanmoins aussi un cycle de reproduction sexué, nommé la gamétogonie.
Le trypanosome n’utilise que la reproduction asexuée (la fission) mais passe par différentes formes cellulaires lors de son cycle de vie.

De nombreux protistes pratiquent également la reproduction sexuée. Les espèces qui ne se reproduisent que par reproduction asexuée n’ont soit jamais acquis de reproduction sexuée, soit l’ont perdue secondairement, au cours de l’évolution. On distingue trois types de cycle de vie chez les organismes à reproduction sexuée, en fonction de l’importance relative de la phase haploïde et de la phase diploïde. Certaines espèces sont principalement haploïdes quand le zygote (diploïde) subit directement une méïose pour former des cellules filles à nouveau haploïdes (schéma en haut). C’est le cas notamment de Volvox. D’autres espèces sont principalement diploïdes quand seuls les gamètes sexuels sont haploïdes, toutes les autres étapes du cycle de vie étant assurée par une forme diploïde (schéma central) ; c’est le cas notamment des Paramécies. Enfin, il existe des espèces qui alternent diploïdie et haploïdie de façon équilibrée, on parle alors de cycle « co-dominant haplo-diploïde » (schéma en bas), comme chez les Foraminifères et les algues.

Nous prendrons un dernier exemple chez les Ciliés pour vous montrer un processus sexuel remarquable appelé conjugaison. Voyez ici : deux Paramécies. Les Ciliés sont des Protistes de grande taille, beaucoup d'espèces mesurent 100 micromètres et quelques-uns dépassent le millimètre. Confrontés aux problèmes ardus de la gestion d'une grande masse cytoplasmique et de la reproduction sexuée, ils les ont résolus d'une manière originale. Ils ont deux noyaux. Un noyau volumineux, le macronoyau est polyploïde et sert à la gestion quotidienne. Le petit noyau, le micronoyau est diploïde, et reste au repos jusqu'à la phase sexuée dont il est responsable.

Au début de la conjugaison, deux paramécies s'apparient. Attention, 2 individus d’une même fission binaire ne vont pas se conjuguer, que ceux appartenant à des clones différents. Dans chacune des paramécies, le macronoyau dégénère lentement tandis que le micronoyau subit une méiose qui produit 4 micronoyaux haploïdes. Un micronoyau haploïde subsiste, les autres dégénèrent. Ce noyau se divise par mitose, on a 2 micronoyaux dans chaque paramécie. Ensuite il y a échange de micronoyau. Un des noyaux reste sur place tandis que l'autre gagne le cytostome et via les cavités buccales associées passe dans l'autre conjuguant. En même temps, ce dernier fait pareil. Chaque micronoyau migrateur fusionne avec le stationnaire indigène pour donner un micronoyau diploïde dans chaque paramécie. Les conjuguants se séparent et leur micronoyau subit trois divisions par mitose sans cytocinèse produisant huit micronoyaux. Quatre micronoyaux deviennent de nouveaux macronoyaux qui vont rapidement grossir et devenir polyploïde, les quatre autres ne se transforment pas. Après deux cycles de cytocinèse quatre nouvelles paramécies sont formées, chacune avec un nouveau micro- et macronoyau. Ainsi la conjugaison a servi à régénérer le matériel génétique. Ne vous imaginez pas que nous avons vu toutes les modalités de reproduction sexuée, le groupe des Protistes est encore bien plus riche que cela sur ce plan, nous nous contenterons cependant de cet aperçu.

L’étude des différents groupes taxonomiques a pour but, au-delà d’acquérir une culture générale sur la diversité animale, de comprendre comment la complexité et la diversité des organismes présents sur terre s’est mise en place et a évolué. En effet, une problématique majeure en Biologie reste de nos jours de retracer les étapes de complexification morphologique, physiologique et comportementale qui ont permis de passer d’organismes unicellulaires eucaryote tels que les Protistes à des organismes très complexes tels que... les humains.
L’étude des organismes les plus simples structurellement tels que les protistes, les spongiaires et les cnidaires, a dans ce cadre un intérêt particulier, puisqu’ils nous permettent d’imaginer ce à quoi ressemblaient, potentiellement, nos ancêtres. Par exemple, le plan du corps simple des spongiaires, dépourvu notamment d’organes, de muscles et de système nerveux, permet d’imaginer comment, par le passé, notre ancêtre est passé d’un stade unicellulaire tel que les protistes, vers la multicellularité. Comment les cellules qui étaient autrefois des organismes indépendants ont appris à communiquer et à vivre comme une partie d’un corps plus complexe formé de cellules différenciées (ayant des fonctions différentes) (Mann et al, Nature 2010) ?

Quel que soit le groupe taxonomique considéré, cette problématique se résume en trois questions principales :
1) Quelle est l’origine évolutive du groupe taxonomique ? Il s’agit donc ici de retrouver et de caractériser l’ancêtre du groupe étudié, pour identifier les acquisitions de caractères (morphologiques, physiologiques ou autres) qui différencient ce groupe des autres taxa.
2) Quelle est la diversité existante au sein du groupe taxonomique ? Répondre à cette question permet d’identifier les caractères qui définissent l’appartenance au groupe (on distinguera en cours les caractères synapomorphiques des caractères autapomorphiques ). Ces caractères sont ceux pour lesquels il est particulièrement important de comprendre comment et quand ils ont évolué, puisqu’ils correspondent à des étapes évolutives majeures de l’histoire de la vie.
3) Quelles sont les relations de parenté (on parlera de relations phylogénétiques en cours) entre ce groupe taxonomique et les autres groupes étudiés ? Ceci permettra de replacer les caractères du groupe dans la séquence plus large de complexification de la vie, des protistes aux organismes multicellulaires tels que les mammifères.

En ce début de XXIème siècle, les biologistes ont développé différents outils puissants, à savoir la phylogénie et le séquençage à haut débit, qui, combinés aux approches plus classiques, permettent de répondre à ces trois questions :
1) L'étude du phénotype (morphologie, physiologie, comportement... c’est-à-dire tout ce qui participe à l’aspect extérieur de l’organisme) des organismes. Classiquement, on s’intéresse à la morphologie des fossiles qui est alors couplée à l’estimation de l’âge des couches géologiques dans lesquelles ces fossiles sont trouvés. Ceci est possible pour un certain nombre de groupes qui possédaient des structures bien fossilisables, comme les squelettes des Vertébrés, ou parmi les Protistes, le test des Foraminifères.
On utilise aussi le phénotype des organismes vivant actuellement :
* L'étude de l'anatomie d'un animal et la comparaison de ses organes avec ceux des formes qu'on peut considérer comme voisines peuvent être très instructives. Si, par exemple nous comparons le membre d'un Vertébré, au même membre d'un autre animal, il sera raisonnable de conclure que plus la ressemblance est étroite, plus étroite est la parenté probable entre eux. Ce type d'étude utilise la notion d'homologie: idée selon laquelle les organes spécifiques des représentants actuels d'un groupe animal proviennent, après s'être modifiés, d'organes fondamentalement identiques présents chez leurs lointains ancêtres communs.
* L'embryologie aussi, qui est l'étude du développement de l'individu à partir de l'œuf en passant par divers stades embryonnaires, peut contribuer de façon importante à l'interprétation de l'histoire évolutive. Citons un exemple simple: l'homme adulte n'a pas de queue, mais le fait que l'homme provient de Primates plus primitifs possédant cet organe est confirmé par le fait que l'embryon humain a un appendice caudal qui se résorbe ensuite. Nous ferons aussi beaucoup appel à des comparaisons de ce type.
2) L'étude du génotype (ADN, ARN), uniquement des organismes vivant actuellement, s’est développée depuis les années 1980 et est devenue inhérente à toute étude sur l’évolution. Il reste à l’heure actuelle très difficile de séquencer le patrimoine génétique d’organismes morts. Ces dernières années, différentes approches complémentaires ont été développées :
* on a séquencé des gènes présents chez tous les organismes vivants, par exemple le gène ribosomal 18S qui est impliqué dans la production de protéines à partir de l’ARN messager, mais aussi les gènes Hox participant à la mise en place du plan du corps pendant le développement,... Les mutations distinguant les copies de ce gène chez différents organismes permettent en effet par la phylogénie de retracer les relations de parenté entre les groupes, et aussi de dater les époques de différenciation de ces organismes (horloge moléculaire).
* On séquence aussi maintenant le génome complet d’un grand nombre d’organismes, ou une grande partie de celui-ci (séquençage des EST « expressed sequenced tags »). On peut de la même manière retracer les relations de parenté entre organismes par la phylogénomique, c’est-à-dire la phylogénie s’appliquant à un très grand nombre de gènes présents chez tous les organismes étudiés.
*Par ailleurs, le séquençage de génomes complets ou des ESTs de différents organismes permet d’identifier la présence ou l’absence de groupes de gènes impliqués dans des fonctions ancestrales telles que la communication intercellulaire, l’élaboration d’un épithélium,… Si on retrouve ces gènes et qu’ils sont exprimés de façon similaire dans des groupes taxonomiques distants, alors ces organismes partagent un ancêtre commun qui possédait déjà ces gènes, et qui jouaient la même fonction chez ces divers organismes (ces gènes sont dits homologues).

Ces approches doivent en général être combinées afin de répondre à nos questions, comme c’est le cas généralement en science. Un des buts de ce cours est de vous initier à discuter et argumenter l’évolution de la complexification dans le monde animal, sur base de ces outils. Le syllabus, les travaux pratiques, les travaux de groupe à réaliser en cours d’année, ainsi que les cours ex-cathedra mettront l’accent sur cette réflexion.

Dans la discussion des relations évolutives, il est commode d'utiliser des termes comme primitif, supérieur, inférieur, spécialisé. Cependant, ces termes portent à confusion parce qu’il est aisé, bien que faux, de conclure, que l’homme par exemple, est « plus évolué » et « supérieur » aux autres Métazoaires soi-disant « plus primitifs » et « inférieurs ».
Pourquoi est-ce le cas ? Premièrement, il n’y a pas d’évolution vers un but dirigé ou vers un idéal de perfection : les mutations s’accumulent aléatoirement dans le génotype des organismes et seules les mutations bénéfiques à l’organisme sont sélectionnées pour participer à la production de la génération suivante. C’est la base du principe de sélection naturelle. Le hasard seul étant responsable de l’apparition des mutations sur base desquelles l’évolution a lieu, il ne peut y avoir de directionnalité ou de but à l’évolution, tel que l’apparition de l’homme.
Un terme comme primitif est surtout significatif lorsqu'on discute de l'évolution à l'intérieur d'un groupe particulier d'animaux. Par exemple, les espèces primitives sont celles qui possèdent beaucoup de caractéristiques que possèdent aussi leurs ancêtres. Le terme primitif peut être particulièrement malheureux lorsque l'on compare deux embranchements parce que généralement, une seule ou quelques caractéristiques sont considérées. Par exemple, puisque les animaux pluricellulaires se sont développés à partir de formes unicellulaires, les Protistes seraient primitifs vis-à-vis de cette caractéristique, si on les compare aux pluricellulaires. Cependant, d'un autre point de vue, les Protistes ne sont pas nécessairement primitifs comparés aux pluricellulaires puisqu'ils ont atteint une spécialisation intracellulaire inégalée dans les autres groupes.
Le terme spécialisé se réfère habituellement à certaines caractéristiques des espèces qui sont adaptées à une niche écologique particulière. Ce terme cependant ne peut pas faire penser à une idée plus perfectionné, de meilleur. En effet, si certaines espèces possèdent quelques caractéristiques « primitives », la même espèce est fréquemment spécialisée à d'autres égards. Par ailleurs, l’étude croisée de nombreux groupes taxonomiques a révélé que les taxons spécialisés ont une durée de vie généralement plus courte que les groupes plus généralistes, ce qui est attendu puisque les organismes spécialistes s’adaptent plus difficilement aux changements environnementaux que les organismes généralistes.

Examinez l'arbre phylogénétique qui situe les divers embranchements du règne animal. Si l'on dit que les embranchements des Spongiaires et des Cnidaires sont inférieurs, on veut dire qu'ils sont apparus tôt (il y a longtemps donc) au cours de la diversification de la vie, et sont donc situés près de la base de l'arbre. Ceci n'implique pas nécessairement que les groupes supérieurs sont issus directement des Spongiaires et des Cnidaires.
Tout ceci vous paraît certainement difficile à concrétiser maintenant. C'est normal. Nous voulons simplement attirer votre attention sur certains points. Tout au long du cours, nous donnerons des exemples concrets et nous discuterons de tout cela. Relisez de temps en temps ce texte qui se trouve dans votre syllabus.

Depuis l’automatisation des techniques de séquençage de l’ADN, on a utilisé cette approche pour séquencer des portions d’ADN, ou le génome complet d’un nombre croissant d’organismes, en particulier ceux de petite taille pour lesquels l’accès aux caractères phénotypiques reste limité. Par exemple, un grand projet de séquençage concerne l’obtention du gène mitochondrial cytochrome oxidase 1 (COX1) pour un exemplaire de toutes les espèces vivant sur terre, de façon à établir l’arbre complet de la vie sur terre avant que, potentiellement, une partie de cette diversité ne disparaisse (voyiez le résultat en direct sur http://tolweb.org/tree/).
Cet arbre démontre deux choses principalement : il existe deux grands types, et non pas un seul, de bactéries : les Eubactéries et les Archées. Ensuite, cet arbre démontre aussi la monophylie des Eucaryotes, c.-à-d. que tous les eucaryotes descendent d’un ancêtre commun. On peut en dire que l’apparition d’un noyau au sein des cellules n’a été inventé qu’une seule fois au cours de l’évolution.
Les plus anciennes traces fossiles des Procaryotes remontent à 3 milliards d’années, mais il s’agit bien surtout d’une limite inférieure : les Procaryotes pourraient être encore beaucoup plus anciens. Les Archées se distinguant des Eubactéries par certains caractères biochimiques, comme la présence dans la membrane cellulaire de lipides très particuliers (liaison éther), ou le mécanisme de réplication de l'ADN. On les trouve dans des environnements extrêmes comme en milieu marin saturé en sel. Les Eubacteries, ou « vraies bactéries », comprennent tous les autres Procaryotes ; leur membrane cellulaire diffère de celle des Archées et leur paroi cellulaire de peptidoglycane contient de l’acide muramique. Ce sont surtout les analyses moléculaires qui ont permis de mettre en évidence le schisme existant au sein des Procaryotes, entre Archées et Eubactéries.

En haut, position et disposition des couches fossilifères contenant des traces de vie pluricellulaires vieilles de 2,1 milliards d’années (d’après El Albani et al dans la revue Nature en 2010). En bas : reconstruction virtuelle de la morphologie externe (à gauche) et interne (à droite) d'un spécimen fossile du site gabonais.
Les Eucaryotes (du grec « eu », vrai et « karyon », noyau) regroupe tous les autres organismes vivants. On avait déjà des traces fossiles d’eucaryotes unicellulaires vieilles de 1,9 milliards d’années. On a récemment découvert des traces de vie pluricellulaires vieilles de 2 milliards d’années au Gabon, alors que jusqu’en 2009 les premières formes de vie pluricellulaire remontaient à 600 millions d'années environ. Il s’agit de macrofossiles de plusieurs cm de longueur, trop grands et trop complexes pour être des procaryotes ou des eucaryotes unicellulaires.

Etapes :
A - procaryote classique (qui subit un accroissement de taille);
B - invagination de la membrane cytoplasmique;
C - inclusion de petits procaryotes dans de plus gros procaryotes.
L’hypothèse retenue actuellement pour expliquer l’apparition d’organismes eucaryotes, plus récents, à partir de Prokaryotes, plus anciens, est la suivante. On aurait eu d’une part un accroissement de taille des procaryotes, puisque les eucaryotes sont en moyenne 10 fois plus gros que les Procaryotes. On aurait aussi eu une invagination de la membrane cytoplasmique pour produire des organites tels que le reticulum endoplasmique ou la membrane entourant le noyau. Enfin, on imagine l’inclusion de petits procaryotes dans de plus gros procaryotes, les premiers devenant ainsi des organites des seconds, tels que les mitochondries et les chloroplastes. Ceci est la théorie de l’endosymbiose, proposée dans les années 1960 par Lynn Margulis pour expliquer l’origine des eucaryotes unicellulaires (les protistes).

Il ne faut bien sûr pas retenir cet arbre. Quelques observations intéressantes : la plupart des Excavates sont parasites comme le trypanosome Trypanosoma brucei que l’on retrouve chez les Kinetoplastids au sein des Euglénobiontes, ou Trichomonas, un parasite responsable de maladies uro-génitales sévères chez les humains (dans le clade des Trichomonadidae au sein des Euglénobiontes ). Parmi les Rhizaria on retrouve les Foraminifères, ces Protistes à test calcaire dont les traces fossiles servent à la datation des couches géologiques, et dont les espèces vivantes actuellement servent de bioindicateurs de la qualité de l’eau. Les Chromalvéolés regroupent la plupart des algues (diatomées, ..) ainsi que les protistes ciliés comme la Paramécie dans le clade des Ciliés et des protistes parasites tel que le plasmodium (dans le clade Apicomplexés). Parmi les Unicontes, on trouve les amibes (Amoebozoaires), ainsi que les champignons et les Métazoaires (d’après Keeling et al. dans la revue Trends in Ecology and Evolution en 2005).

La phylogénomique (phylogénie appliquée à l’analyse de génomes complets) des Eucaryotes nous révèlent plusieurs choses. Premièrement, la plupart des organismes vivants est de taille microscopique : archées, eubactéries et eucaryotes unicellulaires forment la grande majorité des groupes présents sur l’arbre.
Deuxièmement, vous constatez que la diversité des protistes est telle qu’on a créé plusieurs règnes pour les classer. L’un de ces règnes, celui des Unicontes, englobe les Animaux ou « Métazoaires » qui n’ont plus droit à un règne pour eux seuls. Les Protistes font partie soit du règne des “Plantae” où on retrouve une partie des Protistes photosynthétiques tels que les algues vertes (Chlamydomonas,...), soit des règnes nommés « Excavates », « Chromalvéolés », « Rhizaria » et « Unicontes » dans lequel sont regroupés pour la plupart les Protistes hétérotrophes. Une espèce emblématique de chaque règne est indiquée dans la légende de la figure mais il faut se rendre compte que les relations entre ces Protistes ne se voient pas dans leur phénotype, mais uniquement dans leur génotype.
Troisièmement, on peut constater que les Protistes, dont on retrouve des représentants parmi les Plantae, et les Unicontes et qui forment l’ensemble des Excavates, des Rhizaria et des Chromalvéolés, est donc un groupe « paraphylétique », tout comme celui des « Invertébrés ». Ceci signifie qu’il n’existe pas un seul groupe comprenant tous les Protistes, et donc qu’il n’existe pas de caractères qui permettent de distinguer les protistes de tous les autres organismes vivants de façon définitive (pas d’autapomorphies, ou de synapomorphies). Le terme « Protiste », tout comme le terme « Invertébré », est utilisé à défaut de mieux, à l’heure actuelle en Biologie.

Les Unicontes nous intéressent plus particulièrement puisque c’est dans ce groupe que se retrouvent les Métazoaires. On a ainsi découvert qu’un groupe de Protistes à collerette, les Choanoflagellés, sont le clade sœur des Métazoaires. C’est donc au sein des Unicontes qu’on trouve l’origine de la vie animale.
Qui sont les Choanoflagellés ? Il en existe 600 espèces ; d’une taille d’environ 10 µm, ils sont petits, et vivent en eau douce et en eau de mer, sous forme fixée ou libre, solitaire ou coloniale. Les formes coloniales sont formées de cellules juxtaposées, mais non différenciées morphologiquement. Au-delà de leur position dans l’arbre de vie à côté des Métazoaires, les Choanoflagellés possèdent quelques caractéristiques phénotypiques et génotypiques qui soutiennent l’idée qu’ils sont à l’origine de la vie animale pluricellulaire. En effet, la structure morphologique d’un Choanoflagellé est très proche de celle qu’on retrouve chez une cellule typique des Eponges, le choanocyte. Vous en apprendrez davantage sur les choanocytes dans le chapitre suivant. Par ailleurs, le génome du premier Choanoflagellé Monosiga brevicollis a été séquencé en 2008 (King et al., 2008 dans Nature) et son analyse révèle l’existence de nombreux gènes qu’on considérait auparavant comme spécifiques (uniques) aux Métazoaires. Ces gènes sont impliqués dans les interactions intercellulaires des corps multicellulaires ainsi que dans le développement des Métazoaires. Par exemple, c’est le cas des tyrosines kinases, ces protéines impliquées dans la régulation de la prolifération cellulaire, ainsi que la différenciation, l’adhésion et la mobilité cellulaires chez les animaux. Ceci indique que les « outils génétiques » nécessaires pour permettre la mise en place de la multicellularité étaient déjà présents dans le génome des premiers Opisthokontes, avant que la multicellularité n’apparaisse réellement.
Lorsqu’on y réfléchit, on se rend compte que différents types cellulaires sont apparus d’abord temporellement, au cours du cycle de vie des espèces, plutôt que spatialement, par juxtaposition de types cellulaires distincts au sein d’un même organisme. Ceci suggère que la mise en place de la multicellularité aurait pu se faire par la juxtaposition de types cellulaires initialement transitoires, s’intégrant pour former un premier Métazoaire.